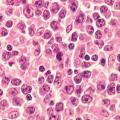

Calcul de whewellite de morphologie Ia
LITHIASE URINAIRE
Image
Cristaux de whewellite révélant une hyperoxalurie
LITHIASE URINAIRE
Image
Ménisque latéral discoïde
LESIONS PERI-ARTICULAIRES
LESIONS LIGAMENTAIRES
Image
Fracture équivalent bimalléolaire
LESIONS PERI-ARTICULAIRES
LESIONS LIGAMENTAIRES
Image
Classification des lésions méniscales à l'imagerie
LESIONS PERI-ARTICULAIRES
LESIONS LIGAMENTAIRES
Image
Fracture bimalléolaire
LESIONS PERI-ARTICULAIRES
LESIONS LIGAMENTAIRES
Image
Urticaire commune superficielle
URTICAIRE COMMUNE SUPERFICIELLE
Image
Pose de ventouses
POSE DE VENTOUSES
Image
Hernie iguino-scrotale irréductible non étranglée.
HERNIE INGUINALE
Image
Hernies piézogéniques des pieds
PIED
TALON
TISSUS ADIPEUX
PAPULES PIEZOGENIQUES DES PIEDS
Image
Psoriasis en gouttes
PSORIASIS
Image
Méralgie paresthésique
SYNDROME CANALAIRE
MERALGIE PARASTHESIQUE
MEMBRE INFERIEUR
NERF FEMORO-CUTANE
Image
Syndrome de l’os trigone
TALUS
MALFORMATIONS
Image
Myopathie myofibrillaire
MYOPATHIE MYOFIBRILLAIRE
MEMBRES INFERIEURS
AMYOTROPHIE
PIED CREUX
Image
Lichen striatus albus
LICHEN PLAN
Image
Plaque typique de psoriasis.
DIAGNOSTIC
EVALUATION DES SYMPTOMES
PSORIASIS
Image
Lymphome T cutané : syndrome de Sézary
SYNDROME DE SEZARY
Image
Lymphome diffus à grandes cellules B
LYMPHOME B DIFFUS A GRANDES CELLULES
HISTOLOGIE
Image
Lymphome diffus à grandes cellules B
LYMPHOME B DIFFUS A GRANDES CELLULES
HISTOLOGIE
Image
Endométriose ovarienne
ENDOMETRIOSE
Image
Endométriose pelvienne profonde
ENDOMETRIOSE
Image
Goutte
ARTHROPATHIES A CRISTAUX
Image
Calcification de l'épaule
ARTHROPATHIES A CRISTAUX
Image
Tendinopathie calcifiante de l'épaule
TENDINOPATHIE
ARTHROPATHIES A CRISTAUX
Image